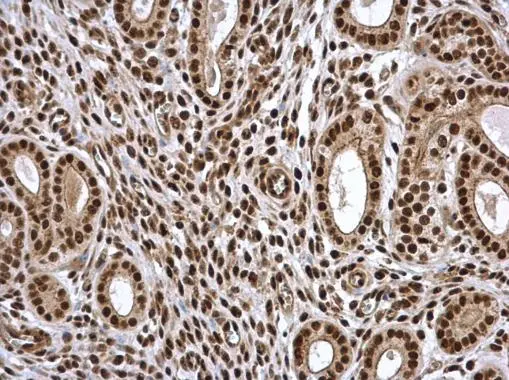
PSME3 antibody detects PSME3 protein at nucleus in mouse cervix by immunohistochemical analysis. Sample: Paraffin-embedded mouse cervix. PSME3 antibody (GTX106722) diluted at 1:500. 
 Antigen Retrieval: Citrate buffer, pH 6.0, 15 min

Sample (30 μg of whole cell lysate) A: A549 B: H1299 C: HCT116 D: MCF-7 12% SDS PAGE GTX106722 diluted at 1:2000. The HRP-conjugated anti-rabbit IgG antibody (GTX213110-01) was used to detect the primary antibody.
PSME3 antibody
GTX106722
ApplicationsImmunoFluorescence, Western Blot, ImmunoCytoChemistry, ImmunoHistoChemistry, ImmunoHistoChemistry Paraffin
Product group Antibodies
ReactivityHuman, Mouse, Rat
TargetPSME3
Overview
- SupplierGeneTex
- Product NamePSME3 antibody
- Delivery Days Customer9
- Application Supplier NoteWB: 1:500-1:3000. ICC/IF: 1:100-1:1000. IHC-P: 1:100-1:1000. *Optimal dilutions/concentrations should be determined by the researcher.Not tested in other applications.
- ApplicationsImmunoFluorescence, Western Blot, ImmunoCytoChemistry, ImmunoHistoChemistry, ImmunoHistoChemistry Paraffin
- CertificationResearch Use Only
- ClonalityPolyclonal
- Concentration0.65 mg/ml
- ConjugateUnconjugated
- Gene ID10197
- Target namePSME3
- Target descriptionproteasome activator subunit 3
- Target synonymsHEL-S-283, Ki, PA28-gamma, PA28G, PA28gamma, REG-GAMMA, proteasome activator complex subunit 3, 11S regulator complex gamma subunit, 11S regulator complex subunit gamma, Ki antigen, Ki nuclear autoantigen, REG gamma-3, activator of multicatalytic protease subunit 3, epididymis secretory protein Li 283, proteasome (prosome, macropain) activator subunit 3 (PA28 gamma; Ki), proteasome activator 28 subunit gamma, proteasome activator 28-gamma
- HostRabbit
- IsotypeIgG
- Protein IDP61289
- Protein NameProteasome activator complex subunit 3
- Scientific DescriptionThe 26S proteasome is a multicatalytic proteinase complex with a highly ordered structure composed of 2 complexes, a 20S core and a 19S regulator. The 20S core is composed of 4 rings of 28 non-identical subunits; 2 rings are composed of 7 alpha subunits and 2 rings are composed of 7 beta subunits. The 19S regulator is composed of a base, which contains 6 ATPase subunits and 2 non-ATPase subunits, and a lid, which contains up to 10 non-ATPase subunits. Proteasomes are distributed throughout eukaryotic cells at a high concentration and cleave peptides in an ATP/ubiquitin-dependent process in a non-lysosomal pathway. An essential function of a modified proteasome, the immunoproteasome, is the processing of class I MHC peptides. The immunoproteasome contains an alternate regulator, referred to as the 11S regulator or PA28, that replaces the 19S regulator. Three subunits (alpha, beta and gamma) of the 11S regulator have been identified. This gene encodes the gamma subunit of the 11S regulator. Six gamma subunits combine to form a homohexameric ring. Two transcript variants encoding different isoforms have been identified. [provided by RefSeq]
- ReactivityHuman, Mouse, Rat
- Storage Instruction-20°C or -80°C,2°C to 8°C
- UNSPSC12352203
References
- Gu Y, Barwick BG, Shanmugam M, et al. Downregulation of PA28α induces proteasome remodeling and results in resistance to proteasome inhibitors in multiple myeloma. Blood Cancer J. 2020,10(12):125. doi: 10.1038/s41408-020-00393-0Read this paper
- Huang ZN, Her LS. The Ubiquitin Receptor ADRM1 Modulates HAP40-Induced Proteasome Activity. Mol Neurobiol. 2017,54(9):7382-7400. doi: 10.1007/s12035-016-0247-yRead this paper